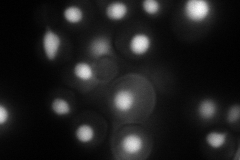
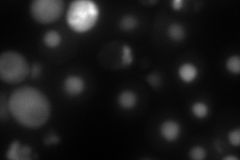
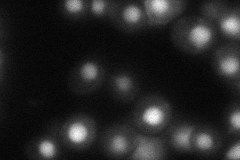
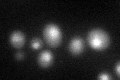
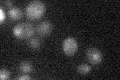

View description
Dihydrouridine synthase, member of a widespread family of conserved proteins including Smm1p, Dus1p, and Dus4p; contains a consensus oleate response element (ORE) in its promoter region
Localization:
Intensity:
Fold change:
Significance:
-
C’ GFP library in SD

nucleus30.14 -
N' NOP1pr-GFP in SD
nucleus117.443 -
N' TEF2pr-mCherry in SD
nucleus112.443 -
N' NATIVEpr-GFP in SD
nucleus48.7988 -
N' TEF2pr-VC and Cyto-VN in SD

#N/A0 -
C’ GFP library in SD+DTT
nucleus25.320.84No -
C’ GFP library in SD+H2O2

nucleus30.471.01No -
C’ GFP library in Starvation Media
nucleus18.150.6Yes -
C’ GFP library on the background of Pup2-DaMP

nucleus -
C’ GFP library on the background of CCT mutant

nucleus31.981.06093No
